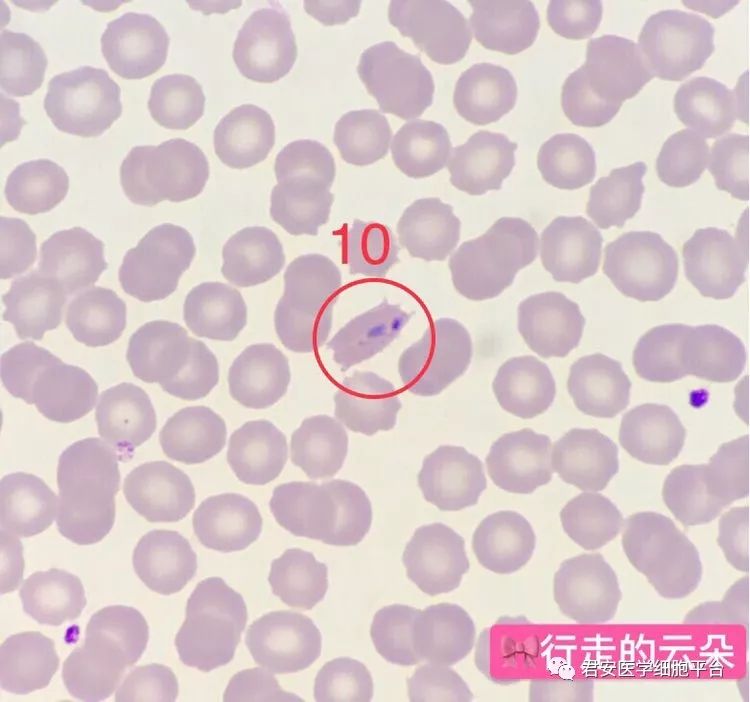
▼「疟原虫环状体」形态特征:感染虫体的红细胞胀大,呈椭圆形伞矢状

椭圆形红细胞

看图识细胞之"卫生部2018年第2次血细胞形态学质控"_报告
图片尺寸701x473
见于哪些疾病 ()a,遗传性椭圆性红细胞增多症b,缺铁性贫血c,恶性贫血
图片尺寸253x258
遗传性椭圆形红细胞增多症
图片尺寸220x218
其他人的都是椭圆形而且很漂亮.可是我的就很奇怪很难看.
图片尺寸768x1024
遗传性椭圆形红细胞增多症
图片尺寸1080x1920
其他人的都是椭圆形而且很漂亮.可是我的就很奇怪很难看.
图片尺寸768x1024
遗传性椭圆形红细胞 增多症
图片尺寸680x510
图 5 遗传性椭圆红细胞增多症 ② 破碎红细胞(裂红细胞,头盔状细胞,红
图片尺寸358x238
遗传性椭圆形红细胞增多症
图片尺寸220x212
遗传性椭圆形红细胞 增多症
图片尺寸680x510
遗传性椭圆形红细胞 增多症
图片尺寸680x510
遗传性椭圆形红细胞 增多症
图片尺寸680x510
检验主管技师辅导红细胞形态异常2
图片尺寸366x275
原始红细胞 18
图片尺寸1080x810
遗传性椭圆形红细胞增多症
图片尺寸200x151
小儿遗传性椭圆形红细胞增多症
图片尺寸496x325
遗传性椭圆形红细胞增多症
图片尺寸220x179
遗传性椭圆形红细胞增多症
图片尺寸220x205
▼「疟原虫环状体」形态特征:感染虫体的红细胞胀大,呈椭圆形伞矢状
图片尺寸750x702
巨红细胞常呈椭圆形,内含血红蛋白量高,中央淡染区常消失.
图片尺寸383x325